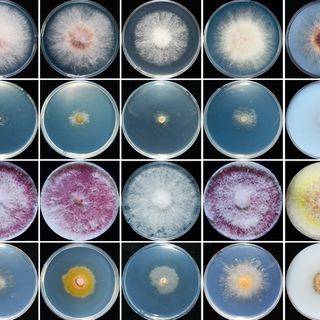
20191010141502_68db76.jpg

来源:BioArt植物
近期,浙江大学农业与生物技术学院生物所赤霉病防控研究团队在PLoS Pathogens上以封面文章发表了题为A fungal ABC transporter FgAtm1 regulates iron homeostasis via the transcription factor cascade FgAreA-HapX的研究论文,揭示赤霉病菌ATP结合蛋白通过转录因子级联调控铁动态平衡的新机制。
在真核生物中,铁的动态平衡在DNA 合成和修复、细胞呼吸、核糖体生物合成等生命活动中起重要作用。因此,真核生物通过长期进化形成了复杂的铁平衡调节机制,精确地调控铁的摄取、消耗和储存。目前,人们对植物病原真菌中铁动态平衡的调控机制尚缺乏深入研究。
近年来,由于气候变化、大面积小麦—玉米轮作和秸秆还田等因素的影响,赤霉病在我国呈加重发生态势,严重影响小麦稳产丰收。此外,病菌产生的多种有毒性的真菌毒素,对人畜健康构成威胁,每年造成上百亿元的经济损失。
该研究发现,ABC蛋白FgAtm1的缺失导致赤霉病菌细胞内铁的大量积累。进一步研究发现, FgAtm1缺失导致细胞质中铁硫蛋白亚硝酸还原酶和黄嘌呤脱氢酶酶活降低,进而激活氮源转录因子FgAreA。FgAreA可以结合铁转录因子FgHapX启动子区,正向调控FgHapX转录。被激活的FgHapX起转录抑制子作用,抑制铁利用基因的表达;此外,FgHapX通过抑制另一个转录抑制子FgSreA,达到激活铁吸收基因表达的作用。本研究揭示重要病原真菌中ABC蛋白通过转录因子FgAreA-HapX级联调控铁平衡的新机制,拓宽人们对真核生物中铁动态平衡调控和ABC蛋白功能的理解和认识。
博士生王芝慧为论文第一作者,尹燕妮教授为通讯作者,马忠华教授为共同通讯作者。
该文转自浙江大学生物所新闻网。论文链接:
https://doi.org/10.1371/journal.ppat.1007791
来源:bioartplants BioArt植物
原文链接:http://mp.weixin.qq.com/s?__biz=MzU3ODY3MDM0NA==&mid=2247492560&idx=3&sn=838b8ea199a2d9722d0bbb86d93adcac&chksm=fd7379b7ca04f0a19ee3ca44ee193f0e16c05542828dbe048c09f2a5e4e72bc88cab7fb0e64d&scene=27#wechat_redirect
版权声明:除非特别注明,本站所载内容来源于互联网、微信公众号等公开渠道,不代表本站观点,仅供参考、交流、公益传播之目的。转载的稿件版权归原作者或机构所有,如有侵权,请联系删除。
电话:(010)86409582
邮箱:kejie@scimall.org.cn